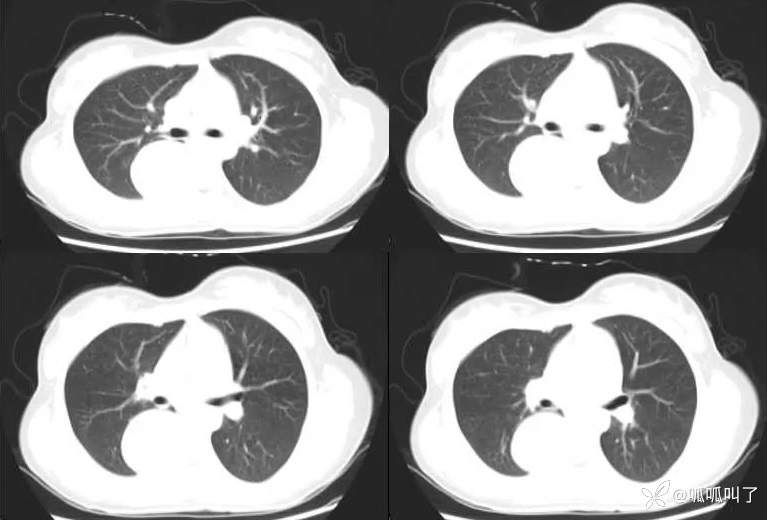
img

2404胸部影像病例|常见病易误诊,来挑战
病例信息
病史:女,17岁,高中学生,学校体检发现纵隔肿物,平素无明显不适症状,建议进一步检查,次日就诊于当地医院行胸部CT提示“右肺下叶脊柱旁占位”,建议入院治疗,后就诊于我院。
既往史:曾患先天性白内障并手术治疗。
DR

CT


病例信息
病史:女,17岁,高中学生,学校体检发现纵隔肿物,平素无明显不适症状,建议进一步检查,次日就诊于当地医院行胸部CT提示“右肺下叶脊柱旁占位”,建议入院治疗,后就诊于我院。
既往史:曾患先天性白内障并手术治疗。
DR

CT